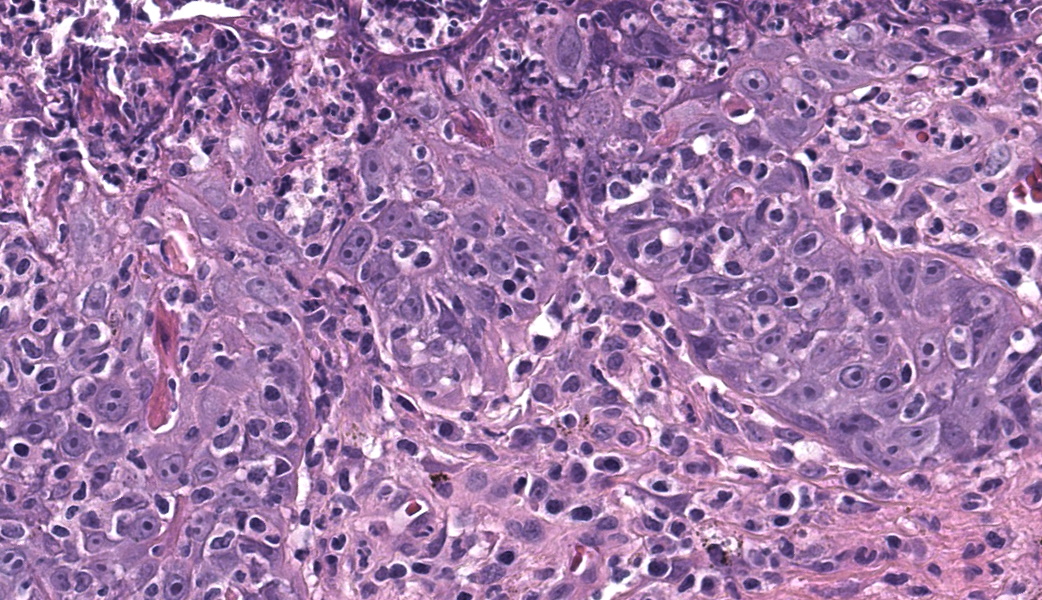

Wednesday Slide Conference, 2025-2026, Conference 9, Case 2
Signalment:
12-year-old neutered male Pomeranian dog (Canis lupus familiaris)History:
Gross Pathology:Four skin biopsy punches from the abdomen, thigh, neck, and chest were received and processed.
Laboratory Results:
N/AMicroscopic Description:
Haired skin. Alle the biopsies are histologically similar. The superficial and mid dermis is obscured by a moderate to severe inflammatory infiltrate, often obscuring the dermo-epidermal junction. The inflammatory infiltrate is represented by a prevalence of lymphocytes and plasma cells, macrophages occasionally engulfing melanin (melanophages), and rare neutrophils. The epidermis is moderately thickened (irregular hyperplasia), with mild intercellular edema (spongiosis) and severe thickening of the stratum corneum by predominantly nucleated (parakeratotic hyperkeratosis) or less frequently non-nucleated keratin (orthokeratotic hyperkeratosis). Numerous apoptotic figures are observed throughout the epidermis, occasionally surrounded by lymphocytic satellitosis. Similar lesions are observed in the hair follicles. There is multifocal erosion or ulceration of the epidermis; the ulcerated areas are obscured by serocellular crusts.Contributor's Morphologic Diagnoses:
MD: Haired skin. Lymphoplasmacytic interface dermatitis, diffuse moderate chronic, with epidermal hyperplasia, numerous suprabasal apoptosis with lymphocytic satellitosis, parakeratosisND: Hyperkeratotic erythema multiforme
Contributor's Comment:
Erythema multiforme (EM) denotes a disease histologically characterized by keratinocyte death (apoptosis) with lymphocytes satellitosis.3 Historically, veterinary EM has been compared to human EM, thus been considered as one end of the spectrum of diseases including Stevens-Johnson Syndrome (SJS) and toxic epidermal necrolysis (TEN).5,6 The terms, ‘erythema multiforme minor’ (EM minor) and ‘erythema multiforme major’ (EM major) have been previously adopted to describe entities with significant differences in the severity of involvement, expressed as percentage of body surface.3 Respectively, EM minor is characterized by target lesions, affecting maximum one mucosal surface, and less than 10% of body surface; EM major involves more than one mucosal surface affected, between 10% and 50% of body surface, with less than 10% epithelial detachment.3 SJS involves more than 50% of body surface, with an epithelial detachment of 10%-30%; TEN is characterized by a generalized disease and more than 30% epithelial detachment.3However, nowadays in human medicine, EM and SJS/TEN are considered different entities, and not a spectrum: EM is considered a separate disease, mostly associated with herpes simplex virus, while SJS and TEN are mostly drug induced. 5,6 Unfortunately, there is no consensus about the criteria for the differentiation of these diseases in veterinary medicine.5,6
EM is a rare disease and has been reported in dogs, cats, horses, cattle, swine, and a ferret.3,5 EM is a multi-factorial disease: adverse drug reaction is traditionally considered the most common cause, but also other triggers have been reported, including neoplasia, parvovirus infection and commercial dog food preservatives, and also idiopathic cases are reported.2-6 EM is presumably a host-specific T cell-mediated hypersensitivity phenomenon directed towards different keratinocyte-associated antigens, thus eliciting the death of the keratinocytes through apoptosis.3
Grossly, EM is frequently characterized by erythematous macules, papules, and plaques with central clearing, usually with acute onset.3.5.6 In later phases, there could be crusts, with a more targetoid appearance, arciform and serpiginous patterns.3 Mucosal lesions include vesicles, bullae, and ulcers.3 Fever and pain may be present. Lesion most commonly involve trunk, groin, and axillae, but may be present anywhere.3
Histologically, EM has the features of a cytotoxic (interface) dermatitis. Necrotic keratinocytes are present throughout the epidermis and the adnexal epithelia, often associated with lymphocytic satellitosis. The dermopidermal junction is obscured by lymphocytes and macrophages. Basal keratinocytes could be degenerated.3,5,6 Hyperkeratosis and parakeratosis are commonly seen in canine EM, as opposed to human EM, and may be severe in persistent forms of EM.6 This latter form is called “hyperkeratotic EM”.1
Based on the morphological features, the differential diagnoses include cutaneous lupus erythematosus, thermal or caustic burns, epitheliotropic lymphoma.3,5
Contributing Institution:
San Marco Veterinary Clinic and Laboratory, Pathology division, Viale dell'Industria 3, 35030, Veggiano (PD), Italy https://www.clinicaveterinariasanmarco.it/JPC Diagnoses:
Haired skin: Dermatitis, cytotoxic-interface, lymphocytic, chronic, marked, with transepidermal keratinocyte apoptosis and parakeratotic hyperkeratosis.JPC Comment:
This classic case of erythema multiforme (EM) was much appreciated by participants as it stimulated great discussion on EM and other top differentials, cytotoxic dermatitis pathogenesis, and a handful of “boards-worthy” information. The contributor’s well-written and thorough comment covers much of what was discussed in conference related to the differences between the human and canine manifestations of EM, so focus will be placed on other major discussion points.The major histologic features to help differentiate EM from other conditions are the presence of suprabasilar and transepidermal apoptosis of keratinocytes and satellitosis of lymphocytes around affected keratinocytes.5 Note, however, that if lymphocytes are instead aggregating in and near the epidermis rather than just hovering around affected keratinocytes, epitheliotropic T-cell lymphoma should rise on the differential list. In EM, epithelial dysplasia may also be seen secondary to the concurrent inflammation and necrosis. The same features of transepidermal apoptosis and lymphocyte satellitosis can also be seen in the follicular epithelium, not just in the epidermis! Follicular epithelium may also exhibit hyperpigmentation and vacuolation secondary to inflammation. Parakeratotic hyperkeratosis is often seen in the hyperkeratotic form of EM but is not considered a key diagnostic feature of EM in general.1,5
Two other top differentials to consider when looking at a case of hyperkeratotic EM (HKEM) are exfoliative cutaneous lupus erythematosus (CLE) and generalized discoid lupus erythematosus (GDLE). CLE can look similar histologically, but will not have transepidermal keratinocyte apoptosis, will lack lymphocyte satellitosis, and won’t have as much hyperkeratosis. GDLE is less proliferative than HKEM with scarring and skin atrophy, neither of which are seen in HKEM. GDLE will also lack the prominent suprabasilar and transepidermal apoptosis and lymphocytic satellitosis seen in HKEM.1 Other diseases that can more closely mimic EM histologically (i.e. have transepidermal apoptosis, lymphocyte satellitosis, etc.) include SJS/TEN, which is typically acute, severe, and may present as diffuse necrosis, and cutaneous drug reactions, which can honestly look like anything.6
Clinical photographs and a thorough history are crucial to dermatopathology cases as a whole and, when it comes to hyperkeratotic EM, can significantly help with diagnosis. Grossly, canine EM typically appears as red papules to plaques that are centrally cyanotic and present on the trunk, groin, and axilla. Hyperkeratotic canine EM, however, can look like raised, hyperpigmented, lichenified plaques in similar locations, but predominantly affects the face and ears. The current school of thought is that hyperkeratotic EM is idiopathic and may target suprabasilar keratinocytes with subsequent proliferation of basilar cells that results in the parakeratotic hyperkeratosis seen histologically.1,6
In keeping with current dermatopathology terminology, EM is classified as a cytotoxic dermatitis. Other entities that fall under this designation include SJS/TEN, graft-vs-host disease, and cutaneous viral infections (i.e. poxvirus). Both EM and SJS/TEN are mediated by cytotoxic CD3+/CD8+ lymphocyte responses against keratinocytes that have been altered either due to infectious agents or drugs.6 Apoptosis results from either direct cytotoxicity or through soluble mediators such as Fas ligand, granzymes, perforin, and granulysin.1,6 For those taking the Phase I exam soon, Fas ligand should ring a bell as the ligand that binds to the Fas death receptor in extrinsic apoptosis.
Although the pathogenesis of EM is not yet fully understood, CD3+/CD8+ lymphocytic cytotoxic responses against keratinocytes are seen in both human and canine EM diseases. In human EM, a recent study found that T-lymphocyte/NK cell cytotoxicity and Janus kinase (JAK)-signal transducer and activator of transcription (STAT) signaling were highly upregulated.1 As such, JAK inhibitors have become a promising source of treatment modality for EM patients, both human and canine. If JAK is inhibited, STAT cannot be phosphorylated and cannot translocate to the nucleus to upregulate target gene transcription. Interferon genes can be targets of the JAK/STAT pathway, so the effectiveness of JAK inhibitors in EM cases may be related to the inhibition of interferon-y and type I interferon production.1
References:
- Banovic et al. “Hyperkeratotic erythema multiforme variant in 17 dogs”. Vet Dermatol. 2023;34(2):125-133
- Favrot C, Olivry T, Dunston SM, Degorce-Rubiales F, Guy JS. Parvovirus infection of keratinocytes as a cause of canine erythema multiforme. Vet Pathol. 2000 Nov;37(6):647-9.
- Gross TL et al. Skin diseases of the dog and cat. Second edition. Blackwell Publishing; 2005; 65-68.
- Itoh T, Nibe K, Kojimoto A, et al. Erythema multiforme possibly triggered by food substances in a dog. J Vet Med Sci. 2006;68(8):869-71.
- Mauldin EA, Peters-Kennedy J. Integumentary System. In: Grant Maxie M, ed. Jubb, Kennedy and Palmer’s Pathology of domestic animals. 6th ed. St. Louis, USA: Elsevier;2016;609-10.
- Yager JA. Erythema multiforme, Stevens–Johnson syndrome and toxic epidermal necrolysis: a comparative review. Vet Dermatol. 2014;25(5):406-e64.